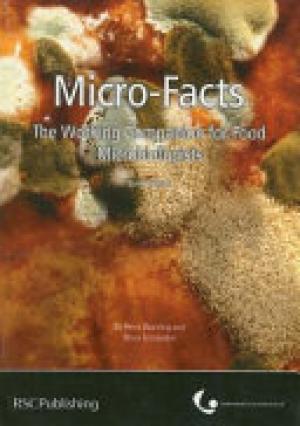
Micro-facts

2007,
Micro-Facts has proved to be a useful ready reference for practising food microbiologists and others...
1989,
The subject matter of this text is conference based and deals with the physiology, ecology and management...
2007,
Nanoethics seeks to examine the potential risks and rewards of applications of nanotechnology. This...
2008,
Introduction to nanofluids--their properties, synthesis, characterization, and applications Nanofluids are...
2008,
This exciting new reference from Dr. Miller, et al provides an expert, illustrative guide to the full...
2007,
Since the early days of integrated pest management a sound ecological foundation has been considered...
1989,
The volume identifies how stressful conditions affect plants. Various stresses can have a major impact on...
2007,
Low molar mass organic materials and polymers exhibit a range of physical properties that are dependent on...
2012,
Fundamentals of Prescott's Microbiology provides a balanced, comprehensive introduction to all major areas...
2015,
A culturally informed book that never loses sight of its fundamental purpose, PUBLIC SPEAKING: CONCEPTS...
2006,
With its clear explanations and illustrative graphics, QuickSteps to Winning Business Presentations is the...
2008,
Real World Drug Discovery: A Chemist's Guide to Biotech and Pharmaceutical Research presents this kind of...
2005,
Real-Life Marketing and Promotion Strategies in College Libraries is a how-to guide to marketing and...
2008,
This translation of a German title, which was enthusiastically received by a wide audience, collects...
2008,
The discovery that RNA could act as a macromolecular catalyst in the cell, signified a paradigm shift in...
2008,
The coverage is wide-ranging and comprehensive and includes the basic structure and functioning of garden...
2007,
The first comprehensive examination of these fascinating proteins ever published. Organized into five...
2008,
This first comprehensive handbook on this exciting field provides readers with a clear understanding of the...
2005,
A thorough reference for researchers who want to overcome the barriers of knowledge and technology, this...
2001,
Our knowledge of the ecology of tropical rain-forest trees is limited, with detailed information available...
2008,
The second edition of this international best seller has been fully revised and updated describing the...
2006,
Philip R. Reilly is a physician, geneticist, and a lawyer. He is also a storyteller. His new book, The...
2007,
Toxoplasma gondii, once an obscure protozoan parasite, has recently become the focus of intense research,...
2004,
Over the past fifty years plant breeders have achieved impressive improvements in yield, quality and...
Books per page:

.png)



















